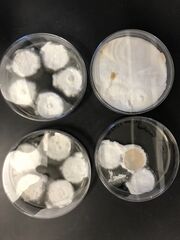
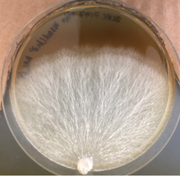
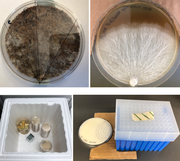

Uploads by Rolando Cruz Perez
From OpenWetWare
Jump to navigationJump to search
This special page shows all uploaded files.
| Date | Name | Thumbnail | Size | Description |
|---|---|---|---|---|
| 21:18, 14 October 2022 | MwM draft Ch4.pdf (file) | 18.17 MB | Black and white draft of chapter 4 of Making with Mushrooms. | |
| 06:06, 14 July 2022 | MwM draft Ch3.pdf (file) | 16.04 MB | Black and white draft of chapter 3 of Making with Mushrooms. | |
| 05:42, 27 June 2022 | MwM draft Ch2b.pdf (file) | 18.83 MB | draft of ch.2, second half. | |
| 05:41, 27 June 2022 | MwM draft Ch2a.pdf (file) | 26.93 MB | draft of ch.2, first half. | |
| 05:39, 27 June 2022 | MwM draft Ch1b.pdf (file) | 24.78 MB | draft of ch.2, second half, reduced file size | |
| 05:35, 27 June 2022 | MwM draft Ch1a.pdf (file) | 16.37 MB | draft of chapter 1, first half | |
| 09:14, 20 June 2022 | MWM draftBW Ch2.pdf (file) | 19.76 MB | Black and white draft of chapter 2 of Making with Mushrooms grpahic novel. | |
| 20:28, 23 May 2022 | MWM Ch1 BW finalDraft.pdf (file) | 22.14 MB | PDF of black and white version of ch. 1 of making with Mushrooms comic. | |
| 03:38, 9 January 2021 | Mycotronics4.png (file) |  |
337 KB | |
| 03:38, 9 January 2021 | Mycotronics3.png (file) |  |
378 KB | |
| 03:37, 9 January 2021 | Mycotronics2.png (file) |  |
281 KB | |
| 03:37, 9 January 2021 | Mycotronics1.png (file) |  |
847 KB | |
| 02:36, 9 January 2021 | Atmtglucliq.jpg (file) |  |
1.9 MB | |
| 02:17, 9 January 2021 | Gluclinfrag fitc.jpg (file) |  |
82 KB | |
| 02:14, 9 January 2021 | Gluc linfrag bf.jpg (file) |  |
180 KB | |
| 02:03, 9 January 2021 | Atmtglucliqres.jpeg (file) |  |
1.51 MB | |
| 02:02, 9 January 2021 | Atmtglucplategel.jpeg (file) |  |
206 KB | |
| 05:00, 8 January 2021 | Atmtglucplate2.jpg (file) |  |
2.08 MB | |
| 04:57, 8 January 2021 | Atmtglucplate.jpg (file) |  |
2.08 MB | |
| 04:45, 8 January 2021 | Agroglucplate2.jpg (file) |  |
2.01 MB | |
| 04:43, 8 January 2021 | Agroglucplate1.jpg (file) | |
2.12 MB | |
| 04:24, 8 January 2021 | Glucprotplas2.jpg (file) |  |
1.88 MB | |
| 04:09, 8 January 2021 | Glucprototrans1.png (file) |  |
11.45 MB | |
| 05:14, 7 January 2021 | Fungisdgs.png (file) |  |
342 KB | |
| 05:13, 7 January 2021 | FungiIndustries.png (file) |  |
317 KB | |
| 05:06, 7 January 2021 | Agrogano1.jpg (file) |  |
2.15 MB | |
| 04:53, 7 January 2021 | Artfungi.png (file) |  |
283 KB | |
| 04:53, 7 January 2021 | Notwfungi.png (file) |  |
266 KB | |
| 04:48, 7 January 2021 | Fungilife.png (file) |  |
274 KB | |
| 04:44, 7 January 2021 | Jreishi2.jpg (file) |  |
473 KB | |
| 04:41, 7 January 2021 | Bf filament.jpg (file) |  |
300 KB | |
| 04:30, 7 January 2021 | Ganoplate.png (file) | |
289 KB | |
| 04:24, 7 January 2021 | Liquidantifungal.jpg (file) |  |
3.29 MB | |
| 04:22, 7 January 2021 | Plategrowth.png (file) | |
432 KB | |
| 04:17, 7 January 2021 | Foray2.png (file) |  |
259 KB | |
| 04:16, 7 January 2021 | Foray1.png (file) |  |
254 KB | |
| 07:59, 6 January 2021 | Agrotrans.png (file) |  |
163 KB | |
| 07:48, 6 January 2021 | Syringesolid.png (file) |  |
566 KB | |
| 07:47, 6 January 2021 | Bagsolid.png (file) |  |
531 KB | |
| 07:46, 6 January 2021 | Jarsolidstate.png (file) |  |
681 KB | |
| 07:44, 6 January 2021 | Liqculture.png (file) |  |
452 KB | |
| 07:41, 6 January 2021 | Plateculture.png (file) |  |
323 KB | |
| 07:36, 6 January 2021 | Distributedmyco.png (file) |  |
370 KB | |
| 07:26, 6 January 2021 | Protoplast40x.jpg (file) |  |
3.07 MB | |
| 07:21, 6 January 2021 | Bf prot release1.jpg (file) |  |
166 KB | |
| 07:18, 6 January 2021 | Bf prot count.jpg (file) |  |
167 KB | |
| 07:02, 6 January 2021 | Ganoantifungal.png (file) |  |
468 KB | |
| 06:26, 6 January 2021 | Ganostump.png (file) |  |
179 KB | |
| 06:25, 6 January 2021 | Mushlitter.png (file) |  |
311 KB | |
| 06:23, 6 January 2021 | Mushpolymer.png (file) |  |
1.01 MB |